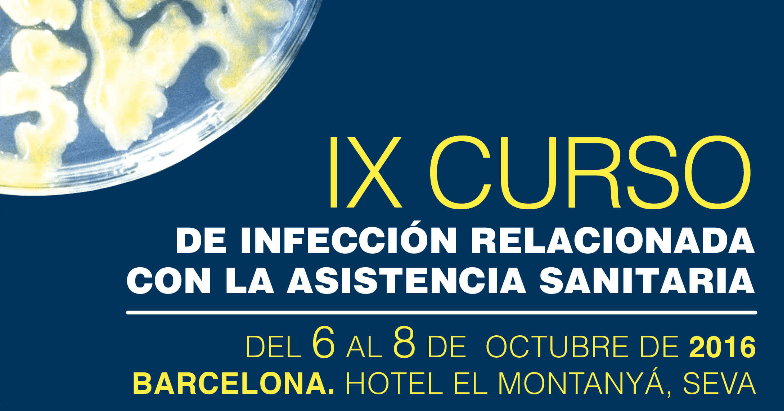
curso GEIH 2016

IX Curso de Infección relacionada con la asistencia sanitaria, a celebrar del 6 al 8 de octubre, en el Hotel Montanyá. Seva (Barcelona)
OBJETIVOS:
1- Ofrecer formación teórica de calidad en temas relacionados con vigilancia, prevención, control y tratamiento de las infecciones relacionadas con la asistencia sanitaria.
2- Dotar de los conocimientos prácticos (a través de talleres) necesarios para poder llevar a cabo las tareas básicas de control de las infecciones relacionadas con la asistencia sanitaria en diversos tipos de hospitales.
DIRIGIDO A:
Médicos especialistas, personal de enfermería, farmacéuticos y profesionales con interés en infecciones relacionadas con la asistencia sanitaria.
METODOLOGÍA:
• Curso intensivo presencial a desarrollar en 3 días
• Máximo 50 alumnos
• Clases teóricas presenciales
• Talleres prácticos en grupos.
Cartel del curso
https://drive.google.com/open?id=0By_a3n-hfdo0LUg1UnNmRF8yVk0
Programa científico
https://drive.google.com/open?id=0By_a3n-hfdo0cC1XUFBIdFFJM0U
Talleres prácticos
https://drive.google.com/open?id=0By_a3n-hfdo0Ny15T212QlFKR2c
Página web
http://eventos.aymon.es/cursogeih2016/